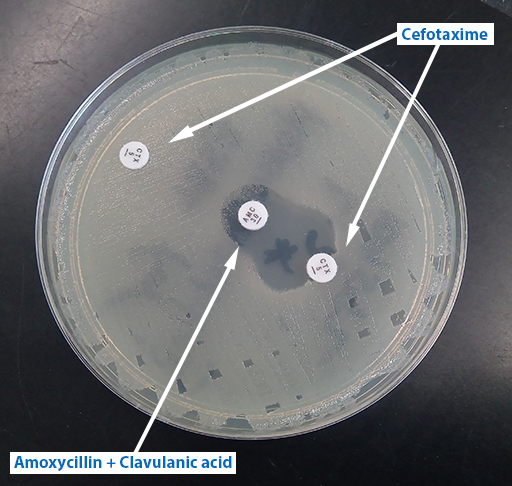

In this course you will learn about phenotypic and genotypic laboratory techniques that are used to test for common mechanisms of antimicrobial resistance (AMR). World Health Organization (
You will start by looking at resistance patterns of global concern in human and animal health, and the importance of knowing the underlying resistance mechanism involved. You will further learn how data derived from screening for specific resistance mechanisms and confirmatory testing, differs from
Basic knowledge of concepts such as the emergence and spread of ‘
By the end of this course you should be able to:
In order to achieve your digital badge and Statement of Participation for this course, you must:
The quiz allows up to three attempts at each question. A passing grade is 50% or more.
When you have successfully achieved the completion criteria listed above you will receive an email notification that your badge and Statement of Participation have been awarded. (Please note that it can take up to 24 hours for these to be issued.)
Before you begin this course, think about your current level of knowledge and skills in the areas covered in this course. You will have an opportunity to repeat this activity when you have completed the course. Do not worry if you lack confidence in some areas, they may be knowledge areas and skills that you are hoping to develop by studying this course. For areas where you feel fully confident, it is always a good idea to refresh and update knowledge and skills.
Use the interactive tool to rate your confidence in these areas using the following scale:
This is for you to reflect on your own knowledge and skills you already have.
Bacteria isolated from clinical sources and animals may have acquired resistance to one or more antimicrobials. A minority of these are both
Of the thirteen WHO-listed human pathogens which are the focus of the Global Antimicrobial Resistance Surveillance System (
In contrast, different bacteria are the main focus of active AMR surveillance in healthy animals, of which some are commensals and some zoonotic pathogens (EFSA, n.d.; FAO, n.d.). In some countries, such as France, Denmark and the USA, bacterial pathogens from certain animal species are included in routine AMR surveillance, for example, livestock-associated MRSA in pigs and Salmonella in cattle (CDC, 2019; DVFA, n.d.). AMR data on these bacterial pathogens are generated from routine laboratory investigations when animals display clinical disease and from controls at abattoirs on healthy animals.
Can you recall the names of any GLASS pathogens? [For clinicians]
The thirteen key bacterial pathogens identified by WHO as the focus of GLASS AMR surveillance programmes are:
Can you recall the names of any commensal or pathogenic bacterial flora in animals which are important causes of zoonotic infection and/or introduction of resistant bacteria via the human food chain? [For veterinarians]
Organisms of concern include:
For background information see the EFSA Panel on Biological Hazards (2009) and WHO (2018).
The WHO (2024) has also developed a different list of specific organism-resistance combinations which have the most urgent need for research and development (R&D) into new treatment approaches.These include 24 pathogens from 15 bacterial families, many of which are gram-negative bacteria resistant to last-resort antibiotics, such as drug-resistant mycobacterium tuberculosis, and other high-burden resistant pathogens such as Salmonella, Shigella, Neisseria gonorrhoeae, Pseudomonas aeruginosa and Staphylococcus aureus. These organisms listed are
Priority 1: CRITICAL
Priority 2: HIGH
Priority 3: MEDIUM
Why do you think these organisms were chosen?
Selection criteria for the WHO priority R&D pathogen list (WHO, 2024) were:
Review Table 1 below and compare the organisms featured on the WHO GLASS and the R&D lists and make notes of any similarities and differences. What are the reasons for any differences between the two lists?
| GLASS pathogens | WHO R&D pathogens |
|---|---|
| E. coli | Acinetobacter baumannii |
| Klebsiella pneumoniae | Enterobacterales – carbapenem-resistant, ESBL-producing |
| Acinetobacter spp. | Enterobacterales – third generation cephalosporin-resistant |
| S. aureus | Mycobacterium tuberculosis |
| Streptococcus pneumoniae | Enterococcus faecium |
| Salmonella spp. (non-typhoidal) | Staphylococcus aureus |
| Salmonella enterica serovar Typhi | Salmonella species (non-typhoidal) |
| Salmonella enterica serovar Paratyphi A | Salmonella Typhi |
| Shigella spp. | Neisseria gonorrhoeae |
| Neisseria gonorrhoeae | Pseudomonas aeruginosa |
| Pseudonomonas aeruginosa | Shigella spp. |
| Neisseria meningitidis | Group A Streptococci |
| Haemophilus influenzae | Group B Streptococci |
| Streptococcus pneumoniae | |
| Haemophilus influenzae |
You will have noticed that there is some overlap between the lists but also some striking differences.
At a basic level, the GLASS list applies to species and looks at a range of resistance mechanisms rather than specifying single species-AMR combinations. This is because the lists serve different functions.
The WHO priority R&D list is about the need for new antimicrobials. It addresses the most concerning resistant organisms known currently. Some of these, like fluoroquinolone-resistant Salmonellae are mainly found in the community while others, for example VRE E. faecium, are mostly found in tertiary care settings.
In contrast, GLASS monitors a wider range of agents as its purpose is to track the development and spread of AMR overall including new patterns of resistance important in human medicine. GLASS is concerned with AMS and the organisms on the list are common and widespread. They can be cultured in most hospital microbiology laboratories, monitored and potentially controlled by good infection control and AMS.
Some rarely encountered organisms like VRSA are commonly tested for in clinical laboratories.
Which pathogen-resistance combinations in the WHO priority R&D list are also important from a
The WHO R&D priority list includes several pathogens of One Health importance which are found in livestock:
Think about the organisms your laboratory identifies routinely. Referring to the GLASS and WHO priority R&D lists, what are the most important organism-resistance patterns that you see in your workplace? Are any combinations associated with outbreaks, for example in Critical Care? Do you see any patterns regularly which are not on the lists? If you routinely perform AST, would your laboratory currently be able to detect the resistance profiles of concern? Make notes and then compare with the example answer.
It is likely that you encounter MRSA and ESBL-producers as these are very common, as well as carbapenemase producers if you live in a part of the world where these are established. If you have a Critical Care Unit in your hospital or laboratory you are likely to have seen outbreaks with some of the MDR Gram negatives.
Think about the organisms your laboratory identifies routinely. Have you had experience in detecting any of the organisms from the WHO R&D priority list in your laboratory? If you routinely perform AST, would your laboratory currently be able to detect the resistance profiles of concern? Make notes and then compare with the example answer.
You are likely to be identifying the coliforms and enteric pathogens. Resistance is surprisingly common if you test for it, both in animals which have been treated with antimicrobials and in those which have not. The strains are readily transmissible and can be spread from other animals via the environment or from humans, hence the need to test for resistance.
Most of the GLASS and WHO priority R&D pathogens, including those of One Health importance, can be cultured easily; some have specific growth requirements (see the Isolating and identifying bacteria course). Some of the resistance patterns can be identified by routine AST; others, for instance ESBL production or VRE, may need additional testing to identify and confirm their presence. You will find out more about these methods later in the course.
The resistance mechanisms that bacteria have evolved to counter the action of antimicrobials are sophisticated. In the Introducing antimicrobial resistance course you learned about the main mechanisms of antimicrobial resistance. See if you can remember them in Activity 5.
Figure 2 shows an overview of the main mechanisms of antimicrobial resistance. Use the drop-down list to match the mechanism to the appropriate part of the diagram.

Unlike hydrolysing enzymes which in general provide high levels of resistance, some mechanisms only produce low-level resistance on their own. However, different mechanisms can combine to increase the level of resistance provided. For example, porin loss combined with an over-expression of efflux pumps can lead to carbapenem resistance which is hard to distinguish on AST from the hydrolysing activity of a carbapenemase, and which has the same effect clinically in reducing the efficacy of treatment.
The β-lactam-hydrolysing enzymes are interesting in that they can sometimes be blocked by using a second substance along with the antimicrobial. This enzyme blocker is called an
Some species of bacteria have
From your study of the Introducing antimicrobial resistance course what can you remember about the role plasmids play in the spread of antimicrobial resistance? Make notes in the text box provided.
Resistance can be shuffled between chromosomal and plasmid DNA on small mobile genetic elements, facilitating recombination and promoting the rapid evolution of new resistant forms. Resistance genes can remain on the plasmid or be integrated into the chromosome; chromosomal mutations can also find their way onto plasmids. This, coupled with
The current greatest AMR threat to modern medicine is from plasmids with a carbapenemase gene plus resistance to multiple antimicrobials. In any of the three organisms in the WHO ‘critical’ R&D category, carbapenem-resistance leads to infections that can only be treated with combinations of drugs or toxic ‘third line’ antimicrobials, for example, colistin. These plasmids can lead to untreatable infections, hence the high priority placed on these pathogen-AMR combinations.
In this section we will explore in more detail some of the specific pathogen resistance patterns in human and animal health.
Gram-negative pathogens are a significant cause of morbidity both in community-acquired infection such as enteric fever and urinary tract infection (
In animal health, Gram-negatives are found as gut commensals and as pathogens. They are an important source of resistance genes getting into the human food chain, especially as it is hard to totally prevent contamination of meat with faecal material at slaughter.

Production of β-lactamases and carbapenemases are the biggest problem with infections caused by Gram-negative organisms owing to the relative lack of antimicrobials available outside these classes to treat them. Quinolone resistance is also a problem.
The resistance genes for β-lactamases are located either on the bacterial chromosome or on plasmids, leading to both intrinsic and acquired resistance. The genes have mutated and evolved so that each one represents a ‘family’ of related genes. Two separate systems are used to classify β-lactamases: a structural scheme based on primary structure (Ambler, 1980; Hall and Barlow, 2005); and a functional scheme based on chemical reactivity and DNA sequence (Bush and Jacoby, 2005).
ESBL-producers among Enterobacterales are significant as they cannot be treated with the usual ‘
ESBL-producers, mainly E. coli and Klebsiella, are also widely distributed in poultry, including those which have had little direct exposure to antimicrobials themselves. They are readily transmitted to humans via food consumption, for example by handling uncooked meat or consuming vegetables fertilised with animal manure; they can also be transferred in the other direction from humans to livestock (Subramanya et al., 2020; Uttapoln et al., 2019).
Table 2 Cephalosporin hydrolysing enzymes important in human and animal health
The greatest current concern for human health is from carbapenem resistance. For example, Acinetobacter, Klebsiella and Pseudomonas aeruginosa are important causes of outbreaks in tertiary and critical care. MDR- and pan-resistant strains are a problem in many critical care units. They are frequently resistant not just to carbapenems but also to all other available antimicrobials. Once they have colonised the environment in a unit, they are very hard to get rid of.
Carbapenem-resistant Enterobacterales (CPE), predominantly Klebsiella and E. coli, have been found in wild animals, livestock and pets, with evidence of direct transfer to humans (Kock et al., 2018).
The main classes of carbapenemases of clinical and veterinary importance are shown in Table 3.
| Carbapenemase class | Notes |
| KPC | Found worldwide, particularly associated with Klebsiella |
| VIM | Metallo-β-lactamases mainly found in Pseudomonas |
| IMP | Metallo-β-lactamases found in Pseudomonas, Acinetobacter and Enterobacterales |
| NDM | Metallo-β-lactamases most common at present in India and the Middle East in Enterobacterales but spread to many species. |
| OXA-48 | Most common carbapenemases in many parts of the world and evolving and spreading rapidly. Most important in K. pneumoniae and E. coli but also found in Pseudomonas where they are harder to detect. They can be missed if carbapenemase screening is not done correctly. |
Table 3 Carbapenemases important in human and animal health (abbreviations: KPC – Klebsiella pneumoniae carbapenemase; VIM – Verona integron-encoded metallo-beta-lactamase; IMP – Imipenemase metallo-beta-lactamase; NDM – New Delhi metallo-β-lactamase; OXA-48 – Oxacillin-48 carbapenemase)
Fluoroquinolone antimicrobials are available orally including for severe infections. They can be used for intracellular organisms – in particular, S. typhi against which many other antimicrobials are not effective as they are unable to enter the mammalian cell – and are a very useful class of antimicrobials. However, fluoroquinolone resistance among Gram-negative organisms is widespread and two pathogen-AMR combinations are listed in the WHO ‘high’ category for R&D priority: fluoroquinolone-resistant Salmonellae and Campylobacter species. Fluoroquinolone-resistant Shigella species are of ‘medium’ R&D priority. Resistance is mostly via modification of the antimicrobial target, as a result of one or more chromosomal mutations.
Both fluoroquinolone-resistant Campylobacter and Salmonella infections are major zoonoses and there are few antimicrobial treatment options. The infections can easily be acquired from food of animal origin if food hygiene is not strictly applied. In contrast, fluoroquinolone-resistant Shigella infections are not acquired from food animals and in general, only affect humans and other primates. Reliance is on good hygiene and sanitation to prevent spread, so they are widespread in contexts where this is difficult to achieve.
In human health, two
Resistant strains of S. aureus pose a big threat to both human and animal health worldwide, with MRSA S. aureus resistant to β-lactam antimicrobials of particular importance.
MRSA is easily transmitted between patients and is a very important HCAI pathogen globally.
MRSA is also found increasingly in livestock (Livestock-associated MRSA,
Resistance occurs by two main mechanisms. The most common form is due to the presence of the mecA gene on a mobile genetic element carried by all MRSA strains. MecA encodes an altered
This type of resistance is different from staphylococcal β-lactamases. These enzymes only cause resistance to penicillins (pencillin, ampicillin and amoxicillin) and the organism remains susceptible to isoxazolyl-penicillins (flucloxacillin and cloxacillin), and first generation cephalosporins. As such, these basic β-lactamase producers do not pose a public health problem at the moment as they remain relatively easy to treat.
Vancomycin is important against S. aureus as it can be used for MRSA strains or when β-lactams cannot be used. VISA refers to organisms with intermediate resistance while hVISA refers to subpopulations of organisms with intermediate resistance in a single culture. VRSA organisms are fully resistant to vancomycin. VISA, hVISA and VRSA therefore refer to S.aureus strains with varying degrees of resistance to vancomycin and using a number of resistance mechanisms. They have been found in increasing numbers in recent years in isolates from both humans and livestock and are a potential future threat (Al-Amery et al., 2019; Cong et al., 2020; Shariati et al., 2020).
Of greatest concern is the presence of the VanA genes, originally found in
Enterococci are gastro-intestinal commensals of humans and other animals. They are moderately virulent, mainly in the context of healthcare i.e. they are largely a HCAI pathogen, although they can cause urinary tract infection in healthy individuals. They cause infections related to prosthetic materials such as intravascular devices, mechanical heart valves and joint implants, that can be extremely difficult to treat.
VRE strains of Enterococcus, most commonly Enterococcus faecium, cause outbreaks among cancer and critical care patients with infections that are hard to treat and require expensive antimicrobials.
E. faecium is intrinsically resistant to β-lactams, including amoxicillin which is active against other Enterococci such as E. faecalis, which means that the loss of vancomycin sensitivity is important. Other species exist that are intrinsically resistant to vancomycin e.g. E. gallinarum and E. casseliflavus, but these only cause sporadic infections in humans (CDC, 2010).
There are a number of resistant phenotypes and genes involved in VRE, the main ones of clinical concern being those with the vanA phenotype. This is mediated by the vanA
Enterococci of animal origin are important from the One Health perspective as a source of resistance genes entering the human food chain.
High-level penicillin resistance in S. pneumoniae can lead to treatment failure in respiratory tract infections. Even low-level resistance is a problem for infections of the central nervous system, for example meningitis. This is because only small concentrations of drug can be achieved in the brain because of the presence of the blood-brain barrier (Linares et al., 2010).
Penicillin resistance in S. pneumoniae is acquired differently to the resistance mechanisms described so far. It is generally the result of cumulative mutations and resistance acquisition leading to resistant strains, rather than by a single transmissible genetic element. An association has often been observed between rates of antimicrobial use and prevalence of resistance in this organism (Albrich et al., 2004; WHO, 2001).
Why is this organism in the ‘medium’ WHO priority R&D category and not in the ‘high’ category?
Although this organism is responsible for life-threatening pneumonia and meningitis, antimicrobial resistance is not as readily transmissible as for some of the other organisms. The resistant strains themselves are transmissible but infection can be controlled by vaccination, and as the strain is removed from circulation so too is its resistance. Most resistant strains remain susceptible to some antimicrobials so can still be treated. MDR S. pneumoniae is an emerging problem (Cillóniz et al., 2018) though, so it could be upgraded in a future list (WHO, 2001).
Haemophilus influenzae is a cause of vaccine-preventable invasive disease (HiB) in children, mainly causing respiratory tract infection or meningitis. Despite the ongoing success of the global vaccine programme, resistance to amoxicillin, in both HiB and non-typeable H. influenzae (NTHi) strains, remains a problem as amoxicillin would normally be the treatment of choice (Su et al., 2020; Van Eldere et al., 2014).
MDR isolates of N. gonorrhoeae are increasing, with fluoroquinolone resistance a particular problem as these infections may not have any treatment options.
Resistance to third generation cephalosporins (ceftriaxone) is also starting to lead to strains which are almost impossible to treat, even with intramuscular injection of antimicrobials rather than oral ones (Costa-Lourenço et al., 2017).
Why might it be important to know what the resistance mechanism is for an isolate, rather than just whether it is susceptible to the antimicrobial you are testing?
Knowing the resistance mechanism is important from both a broader public health and a local infection control perspective. Some resistance mechanisms have more public health consequences than others, for example MRSA versus beta-lactamase producing S. aureus (see section 3.2.1 above) or transmissible
Imagine that a novel pathogen-antimicrobial combination has been found in your country or institution for the first time. What important questions from a public health or infection control perspective need answering? How might knowing the underlying resistance mechanism(s) of the isolate help answer these questions?
Make notes in the text box below before looking at the example answer.
Important questions include:
Once AST has confirmed that a bacterial isolate is resistant to antimicrobial(s), two approaches can be used, either separately or in combination, to identify the resistance mechanism involved ‒
Phenotypic tests focus on characteristics of the bacteria (i.e. phenotype) that can be readily observed or tested for in the laboratory. They use the results of these observations/tests to infer the resistance mechanism (and thus the gene) involved. In contrast, genotypic tests identify the gene responsible for the resistance directly.
You will learn more about these two approaches in the following sections.

Phenotypic tests are carried out more frequently than genotypic tests as they are easier to perform and require less sophisticated/specialised equipment. They include the following, discussed in more detail below:
Indicator antimicrobials can be used alongside normal AST. The principle of this test is to use the
In these instances, once you know that the organism is resistant to the indicator, you can then extrapolate that it will be resistant to every antimicrobial in that class. However, this only works in a few specific cases. For example, cefoxitin resistance in S. aureus implies mecA is present, so the Staphylococcus must be an MRSA (see Section 3.2.1).
Certain indicator antimicrobials can also be used to detect non-
Some resistance mechanisms are expressed only when induced by the presence of another antimicrobial. These strains can become resistant during antibiotic treatment, so it is important to know if they are present. For certain pathogen-antimicrobial combinations, it is therefore possible to test for the resistance mechanism using a form of AST called the
The ‘D’ test can be used to detect inducible clindamycin (DA) resistance in S. aureus. In Figure 10, erythromycin (E) has diffused into the agar and interfered with the effect of the adjacent antibiotic, DA. The effect of E has been to induce the expression of DA in S.aureus organisms present in the agar and allow the bacteria to grow closer to the DA-impregnated disk. This is shown by flattening of the DA inhibition zone on the side next to the E disk.
See Section 9.1.2 for examples of synergy testing.
Susceptibility panels can be done as individual disk diffusion tests, but in practice they are mostly done using an automated system such as Vitek IITM, SensititreTM or PhoenixTM.
Antigen detection tests are mainly used to identify antibiotic hydrolysing enzymes, such as ESBLs and carbapenemases. The enzymes are detected by lateral flow tests to detect a specific enzyme.
The example test in Figure 12 is negative but has passed the control. A positive test would have a line by ‘T’ as well. Lateral flow tests are easy to perform though sometimes hard to interpret if the test line appears faintly.
Colorimetric tests work on the principle that a substrate changes colour when broken down by an enzyme. This principle is used in chromogenic media (e.g. the commercially available CHROMagarTM agars developed for detection of carbapenemase producers, Acinetobacter, MRSA etc.). As well as having substrates for the enzymes, some of them are also selective, that is they inhibit the growth of susceptible organisms and species which are not of interest and only support those to be isolated. Some also change colour for a particular species so can be used to identify the species as well as the resistance mechanism.
Another example is nitrocefin – a chromogenic cephalosporin – which can be used to screen for β-lactamases (Video 1). Nitrocefin is broken down by all known β-lactamases leading to a colour change from colourless to red and so works as an indicator antimicrobial. Although it can be used to test whether a β-lactamase is present it will not discriminate between types of β-lactamase. It is routinely used to look for β-lactamase in N. gonorrhoeae and H. influenzae.
Genotypic tests are widely recognised as the best way to unambiguously prove that a specific resistance gene is present. They are also the only way of characterising suspected new resistance mechanisms.
Many genotypic tests are only done in research and reference laboratories as they all involve molecular biology techniques. However, a few are available as rapid diagnostic kits for commercial
PCR is carried out using:
Can you name any resistance mechanisms where there are commercial PCR kits available for the detection of the resistance genes? Perhaps your laboratory uses these?
Examples of commercial PCR kits include:
Benefits of commercial PCR kits include accuracy and speed. Days can be saved on turnaround times for results in the clinical setting, allowing appropriate antimicrobial treatment or infection control intervention to start earlier.
However, the negatives include:
Whole genome sequencing (WGS) can also be used to look at the bacterial genome and its associated plasmids. Whole genome sequencing (WGS) is a method for rapid sequencing of the chromosomal DNA and mitochondrial DNA (and chloroplasts DNA in plants). WGS is carried out using next-generation sequencing (NGS) technologies, which allows the rapid generation of large quantities of genomic data.
WGS has primarily been used as a research tool, but Nanopore technology and other technologies which have the potential to offer relatively low cost, rapid sequencing are becomingly more common in district hospitals.
WGS can be used for instance to study a newly identified mechanism of resistance or to study the different genes found in a particular setting. It could be used to understand how the resistant organisms had spread in an institution by constructing a phylogenetic tree of the bacteria in a particular species and seeing how this related to the different plasmids and resistance genes. It is also possible to sequence just the resistance genes, which is a little faster and less complex.
WGS has the potential to become an important tool in pathogen surveillance. However, the challenge in AMR is the timely processing of the large volumes of data, particularly during emergency pathogen outbreaks (Bogaerts, 2021 and Jauneikaite, 2023). As a result, the Surveillance and Epidemiology of Drug-resistant Infections Consortium (SEDRIC, n.d.) working group are working on a series of recommendations on the use of genomic surveillance via WGS for AMR. The working group has identified various advantages and barriers to the use of WGS in AMR.
Healthcare-associated infections in hospitalised patients pose a significant challenge globally. Genomic AMR surveillance of pathogens using WGS from healthcare-associated infections can provide much better identification of the causative agent, such as genomic subtypes. It can also help to identify facility-level trends.
One particular advantage of WGS is its use to investigate outbreaks and to improve support for infection prevention and control in AMR surveillance in healthcare facilities. It can help to identify complex epidemiological patterns, such as the emergence of new strains and expansion of new multidrug-resistant strains.
Despite many advantages, there are still many barriers to WGS in AMR surveillance. The initial set up and running costs can be prohibitive or the equipment difficult to obtain due to poor distribution networks and supply chains.
There are also significant challenges in the analysis and interpretation of the genomic data, which typically requires bioinformaticians. Quality assurance processes for both laboratory sequencing and bioinformatic analysis have still yet to be clearly defined.
More information about WGS can be found in the Whole genome sequencing in AMR surveillance course.
Complete Table 4 below then compare with the example answer.
| Comparator | Phenotypic tests | Genotypic tests |
|---|---|---|
| Speed | ||
| Equipment | ||
| Cost | ||
| Can be used for | ||
| Suitable for laboratory type | ||
| Other Advantages |
| Comparator | Phenotypic tests | Genotypic tests |
|---|---|---|
| Speed | Culture-based tests take 24 hours Some tests, e.g. lateral flow testing, nitrocefin testing, may take only 10-15 minutes. |
Variable: PCR gives results within hours but WGS can take days to read and interpret results. |
| Equipment | Only simple requirements. | Complex – require maintenance. |
| Cost | Low – though still more than basic AST. | High – expensive equipment and maintenance. Reagents are also expensive. |
| Can be used for | Detection of mechanisms in routine clinical and veterinary practice. | Rapid PCR can detect known genes WGS can characterise new ones, but still needs to be carried out in conjunction with phenotypic testing. |
| Suitable for laboratory type | Standard clinical or veterinary diagnostic microbiology laboratory (first line). | Rapid PCR suitable for some diagnostic laboratories. Other tests done in research or reference laboratories (second line). |
| Other Advantages | Clinically useful in real time to guide antimicrobial use, infection control etc.. Does not require prior knowledge of the precise resistance genes. Can perform more tests at one time. |
Use in Epidemiology and Public health: e.g. can distinguish between mechanisms which are likely to spread and those that are not. Use of rapid PCR for hospital infection control to enable measures to be taken quickly e.g. isolating a patient with a carbapenemase-producing organism. |
EUCAST (2017) states that, ‘The need for identification of resistance mechanism and the level of identification needed for public health or infection control purposes may vary both geographically and temporally depending on the prevalence and heterogeneity of different resistance mechanisms’. The resistance mechanisms however do not necessarily confer clinical resistance, and instead, screening of resistance mechanisms may be important for infection control and public health.
Detection of the mechanism in extended-spectrum β-lactamases and carbapenemases in Gram-negative bacilli does not in itself lead to classification as clinically resistant. This is because carbapenemase enzymes may be expressed at differing levels and may have different biochemical properties against β-lactams.
However, many carbapenemase-producing strains, such as Pseudomonas aeruginosa and Klebsiella pneumoniae, may be resistant to a wide range of antimicrobial agents.
AmpC-type cephalosporinases are Ambler class C β-lactamases. They hydrolyse penicillins, cephalosporins and monobactams, which have become important in humans but where originally detected in farm animals. Whilst many Enterobacteriaceae and other Gram-negative bacilli produce AmpCs at a low level, hyperproduction due to genetic changes has conferred resistance to cephalosporins and to penicillin-β-lactamase inhibitor.
Many of the phenotypic and genotypic tests used to identify the resistance mechanism are time-consuming and expensive. Therefore, to reduce the total number of tests performed it is customary to screen for potential resistance mechanisms first and then confirm the mechanism on those isolates that screen positive.
The initial screening tests are done to identify organisms which may have a particular mechanism. This could involve either:
Confirmatory tests then prove whether the organism has the resistance mechanism or not (EUCAST, 2017).
Why is the approach of screening followed by confirmation useful?
Screening for organisms with a resistant phenotype first followed by confirmatory tests for the resistant ones saves time and resources. You can screen large numbers quickly then focus on the resistant ones for the confirmatory tests.
Confirmation is a necessary step to avoid over-reporting of the organisms which do show resistance but do not have the mechanism of concern.

How might you initially screen isolates for the presence of possible resistance mechanisms? Can you give any examples from your own laboratory?
Make notes in the text box and then compare with the example answer.
Using a specific indicator antimicrobial during routine AST of samples is a common approach to determine whether a resistance mechanism is present or not (see Section 5.1).
Examples of where this approach would be useful include:
Another approach would be to use selective media. Commercially available chromogenic media are useful especially for screening samples such as swabs or faecal samples for carriage of resistant organisms.
The choice of screening method depends on what sort of samples you are looking at, for example selective media are used for faecal samples from healthy animals, or as part of routine AST for clinical samples.
Chromogenic media are particularly useful if the specimen is likely to be contaminated with normal flora, for example faecal samples. Why is this?
Selective chromogenic media are useful if the sample has normal flora as they save time. Because only the resistant ones will be growing after overnight incubation, they can be worked on directly without having to subculture and do AST first. The test is less likely to miss the resistant ones which might otherwise be hidden among the normal flora. This method is also useful to screen large numbers of samples, and the higher cost of media is offset by savings in time.
For more information about how specific screening tests work in combination with confirmatory tests in practice, see Section 9.
Once screening has enabled the identification of isolates which may have the resistance mechanism you are investigating, various methods can be used to confirm whether that mechanism is present or not (EUCAST, 2017).
The following sections illustrate how confirmatory tests work in practice for ESBLs, carbapenemases and in Gram-positive organisms.
It is important that the correct antimicrobials are used to screen for ESBLs in routine AST as only some cephalosporins are useful. If the wrong antimicrobial is used the ESBL may be missed. A combination of cefotaxime and ceftriaxone, or cefpodoxime alone will allow all types of ESBL to be detected.
What is the rationale behind this screening strategy?
Neither cefotaxime nor ceftazidime alone will pick up all the ESBLs. For example, CTX-M type ESBLs, which are a common cause of resistance in Enterobacterales, may look falsely susceptible to ceftazidime on disk testing but would be detected by using a cefotaxime disk. Cefpodoxime is useful because it detects all the common ones (mentioned above in section 3.1.1).
To confirm that an ESBL is the cause of the resistance the usual approach is to test for synergy with clavulanic acid for ceftazidime, cefotaxime and cefepime, by one of several methods including:

Key:
How would you interpret the results of the double disk synergy test in Figure 15? Does the test organism have an ESBL?
The test organism has an ESBL.
The cefotaxime is inactivated by the ESBL (no zone) on its own but works ‒ preventing growth and leaving a clear zone – in the part of the agar where the clavulanic acid has diffused out from its disk. The clavulanic acid is protecting the cefotaxime from the ESBL. (Note the clavulanic acid disk contains co-amoxiclav (AMC) so there is also amoxicillin present. This combination has given a small zone around the disk, but not enough for this antibiotic to be useful in clinical practice.)
Alternatives to synergy testing include:
Meropenem is the best indicator antimicrobial to screen for carbapenemases in Gram-negatives. Resistance is implied if the MIC is raised or the inhibition zone size reduced.
It is then necessary to determine whether any resistance detected is due to a carbapenemase and not to a combination of resistance mechanisms. For example:
Confirmation of carbapenemase in Enterobacterales can be done by several methods in basic laboratories:

Other methods are possible in reference and research laboratories:
In non-Enterobacterales such as Acinetobacter, carbapenem resistance is due to a variety of carbapenemases with a range of porins and drug efflux pumps (Hsu et al., 2017). In Pseudomonas resistance is frequently due only to increased efflux or porin loss without a carbapenemase being present. However, carbapenemases are found increasingly in Pseudomonas and as it is hard to discriminate the mechanism in practice; the organism may need to be sent to the reference laboratory if it is important to be sure of the mechanism.
From what you have learned about carbapenemases in the course, how might EDTA, a potent zinc chelating agent, be useful for identifying carbapenemases?
EDTA can be used to identify metallo-β-lactamases as the EDTA will remove the zinc and inactivate the enzymes. It is usually included in interpretative panels. See Section 3.1.1.
Note that meropenem is the best antimicrobial to screen as false positives are much less likely than with other carbapenems. For example, ertapenem could be used in Enterobacterales as it is very sensitive but might over-detect resistance leading to wasting resources in unnecessary confirmatory tests.
Can you recall why it is important to discriminate between different types of MRSA in S. aureus, i.e. mecA derived versus hyper-production of β-lactamase?
Only genuine MRSA strains, i.e. those with an altered penicillin binding protein encoded by mecA or mecC genes, are of major public health and infection control importance. These are the strains likely to lead to treatment failure with β-lactam antibiotics.
Common screening methods for MRSA from swabs include colorimetric tests using chromogenic agar or mannitol salt agar. However, other tests such as the disk diffusion type tests or automated systems can be used, for example for clinical samples from invasive infections (PHE, 2020). Cefoxitin is now the recommended antimicrobial to use to confirm MRSA as it is less affected by conditions than oxacillin or methicillin and also detects mecC strains. Therefore, cefoxitin resistance confirms the MRSA phenotype.
Vancomycin resistance in S. aureus (VRSA) is an uncommon but increasing problem. It is worth learning how to test for it accurately.
You identify a S. aureus strain in your laboratory which you think may be resistant to vancomycin. For example, you may be concerned that a clinical isolate is resistant because the patient (human or animal depending on your laboratory) is not responding to treatment or, if it was collected as part of AMR surveillance, you might be doing routine testing for vancomycin resistance. What can you do to investigate this strain further?
Make notes in the text box and then compare with the example answer.
You should be aware that disk diffusion methods are unreliable and not recommended for testing vancomycin resistance in Staphylococcus. It cannot accurately distinguish between wild type and resistant isolates.
In both situations described you need to find out the MIC of vancomycin for the isolate. This is easiest using automated methods (see the Antimicrobial susceptibility testing course). The test result is then compared to the breakpoint tables or your laboratory
Note: if you are aiming to treat a human patient or if the investigation is part of surveillance in animals with a One Health approach use EUCAST; if the aim is to treat an animal then vetEUCAST/vetCLSI guidelines (CLSI, 2020) should be used. EUCAST tables should tell you the breakpoint is 2 for Staphylococcus.
If the MIC of your Staphylococcus is < or = 2, suggesting susceptibility, the isolate may still have a non-vanA mechanism of resistance (e.g. modified cell wall as a result of exposure to the antimicrobial during treatment or via glycopeptide animal growth promoters used in farming). However, it is reported as susceptible for clinical and surveillance purposes.
If the MIC is >2 (resistant), then vanA is a possibility. In this case, the isolate should be sent to the reference laboratory for further testing which usually involves molecular detection of thevanA genes.
When dealing with strains of Enterococcus resistant to vancomycin (VRE) the important thing is to distinguish between species that are intrinsically resistant to glycopeptide antimicrobials such as vancomycin and have no public health significance, and those which harbour acquired resistance genes.
For acquired resistance genes there are two types:
E. faecium is the most common species to have acquired resistance and the pattern of vancomycin and teicoplanin resistance in this organism can be used to infer the presence of vanA or vanB. Gradient diffusion test strips to measure the MIC are a reliable and straightforward method to use to confirm vanA and vanB(Figure 17).

In Figure 17, is the test organism of phenotype vanA or vanB?
The organism is type vanA because it is resistant to both vancomycin and teicoplanin.
Note that disk diffusion testing is relatively unreliable for many other antimicrobials in Enterococci. It is essential to follow the guidelines very closely. Most antimicrobials do not have breakpoints for these species defined by EUCAST so it is only recommended to test the antimicrobials that do, otherwise you will end up with results that cannot be interpreted.
Which of the following species would need further testing for acquired resistance if they had a raised vancomycin MIC indicating resistance to this antimicrobial: E. gallinarum, E. casseliflavus, E. faecium, or E. faecalis?
As you learned in Section 3.2.3, E. faecium and E. faecalis would both need further testing. The others have intrinsic chromosomally encoded resistance to glycopeptides. They only rarely cause infections, for example in immunosuppressed humans. That is why these organisms are not included in the surveillance schemes.
This example illustrates how important it is to identify the Enterococcal species. However, it is not easy to tell the difference between species on biochemical tests alone. E. faecium and E. faecalis tend to be non-motile while the other species are motile and most isolates of E. casseliflavus/E. flavescens have a distinct yellow pigment, which can be observed by collecting growth from an agar plate on a swab. However, unless the laboratory has access to MALDI-TOF it may be necessary to send isolates to the reference laboratory.
Penicillin resistance of S. pneumoniae is commonly screened for with an oxacillin disk in a simple disk diffusion test. This detects non-wild type organisms if the zone size is reduced implying an increased MIC. If necessary, the MIC is then confirmed by a gradient diffusion test (Figure 18). Normally this would only be done for organisms causing an invasive infection. In general, it is seldom necessary to know the specific mechanism.

What is the MIC reading for the S. pneumoniae isolate in Figure 18? Refer to Table 5 and determine whether the standard dose of benzylpenicillin is suitable for treating a patient with a) pneumonia and b) meningitis.
| Penicillins | MIC breakpoints (mg/L) | |||
|---|---|---|---|---|
| S ≤ | R > | |||
| Benzyl penicillin (indications other than meningitis) | 0.06 | 2 | ||
| Benzyl penicillin (meningitis) | 0.06 | 0.06 | ||
The pneumococcus in Figure 18 has an MIC of 0.5 mg/L. The MIC breakpoint for benzyl penicillin is < 0.06 mg/L so the organism appears to have an altered PBP leading to a level of resistance.
How you report this isolate for surveillance will depend on the breakpoints set out in the reporting instructions.
Globally, data on AMR and mechanisms are far from complete. For example, there are good data from Europe on isolates from humans and the food chain as a result of a longstanding surveillance scheme run by ECDC and EFSA, but even within these data there is variation between countries. If each centre or country only reports a few isolates this can bias the data. For countries without established regional surveillance schemes the existing data are very patchy. This makes it hard to understand the extent and distribution of resistance.
Two types of data are available:
These data are still however far from complete.



Information about the resistance mechanism associated with clinical and veterinary isolates is useful at local, national and international levels.
Locally, for example within a hospital, knowing the mechanism can be helpful in order to track the spread of a particular gene and/or organism. It may also help to identify whether cases are genuinely linked. This can help the infection control team define whether it is a genuine outbreak or just sporadic cases. Additional testing would be needed to confirm whether strains are related, but it is more likely if they have the same resistance mechanism and early actions can be put in place to limit transmission. If it is an outbreak, understanding how the organism has spread makes it easier to work out the best measures to control the outbreak. For example, is it spreading from person to person or via water contamination?
On a national or international scale, data about resistance mechanisms help to identify priorities for additional surveillance and control, and for R&D. The data can enable early intervention to contain resistance mechanisms of global concern. If mechanisms can be prevented from becoming widespread, this reduces risk to patients from infections which are hard to treat and saves money in healthcare. This is even more important in low-resource settings where antimicrobial choices are limited because of financial constraints.

The genotypic data can also be used to help understand how transmission from food animals to the human food chain occurs (an example is shown in Figure 22, where the investigators studied the resistance genes in samples from around the farm environment). This in turn can show how this transmission can be prevented. With good quality data it is much easier to implement mechanisms to prevent transmission. This may involve complex interventions such as political, social, and financial measures which may be costly or have negative impacts on food producers in the short term so might be resisted. Data are essential to give the political drive to intervene.
Antimicrobial resistance mechanism data can also help to understand and control international transmission chains. An example could be medical tourism, where people travel to other countries either for cheaper treatment or for treatment which is not available where they live. They risk bringing back and spreading resistant strains to their home country on their return, especially if they have further hospital treatment. This is an important route of spread of AMR and is also a political issue. Again, having good data is vital in order to control spread by this route.
Finally, linking AMR resistance mechanism data to antimicrobial use is very useful to inform strategies for antimicrobial stewardship (see the Antimicrobial stewardship courses).
In previous courses you learned how microbiology laboratories act as ‘data collectors’ and have an important role in ensuring that test results are accurate, reliable, valid and comparable. You further learned about different
You will learn more about quality control measures in the Quality assurance and AMR surveillance course.
You have now learned about some of the more clinically important mechanisms of antimicrobial resistance and how to test for them.
Based on your existing knowledge and what you have learned in this course, what are the issues and challenges to bear in mind when performing tests to identify the resistance mechanism of isolates? When might you need to send an isolate to the reference laboratory for additional testing?
Make notes in the text box and then compare with the example answer.
Some issues and challenges when identifying resistance mechanisms are listed below, but you may have thought of others:
As long as your laboratory is identifying the species and mechanisms accurately, you can be confident that you are providing reliable data for surveillance. You will then be making an important contribution to fighting antimicrobial resistance both locally and around the world.
Well done – you have reached the end of this course and can now do the quiz to test your learning.
This quiz is an opportunity for you to reflect on what you have learned rather than a test, and you can revisit it as many times as you like.
Open the quiz in a new tab or window by holding down ‘Ctrl’ (or ‘Cmd’ on a Mac) when you click on the link.
In this course you have learned about phenotypic and genotypic laboratory techniques used to test for common mechanisms of resistance in important pathogens. You have looked at resistance patterns of global concern, and you have seen how knowledge of the underlying resistance mechanism feeds into AMR surveillance. At a practical level, you have explored screening and confirmatory tests used for pathogen-resistance combinations relevant to your workplace.
You should now be able to:
Do you remember at the beginning of this course you were asked to take a moment to think about these learning outcomes and how confident you felt about your knowledge and skills in these areas? Now that you have almost completed this course take some time to reflect on your progress and use the interactive tool to rate your confidence in these areas using the following 1-5 scale.
Try to use the full range of ratings shown above to rate yourself.
You’ve now reached the end of this course. If you’ve enrolled on a pathway, please go back to the pathway page and tick the box to confirm that you’ve completed this course. On the pathway page you’ll see both your progress so far as well as the other courses you need to complete in order to achieve your Certificate of Completion for that pathway.
Now that you have completed this course, take a few moments to reflect on your experience of working through it. Please complete a survey to tell us about your reflections. Your responses will allow us to gauge how useful you have found this course and how effectively you have engaged with the content. We will also use your feedback on this pathway to better inform the design of future online experiences for our learners.
Many thanks for your help.
This free course was collaboratively written by Sarah Palmer and Liz Sheridan, and was reviewed by Priya Khanna, Skye Badger, Claire Gordon, Natalie Moyen and Hilary MacQueen. The course was reviewed and updated by Ben Amos, Vikki Haley and Rachel McMullan in 2025.
Except for third party materials and otherwise stated (see terms and conditions), this content is made available under a Creative Commons Attribution-NonCommercial-ShareAlike 4.0 Licence.
The material acknowledged below is Proprietary and used under licence (not subject to Creative Commons Licence). Grateful acknowledgement is made to the following sources for permission to reproduce material in this free course:
Course image: © funtap/123RF
Figure 1: EYE OF SCIENCE/SCIENCE PHOTO LIBRARY
Figure 2: The Open University
Figure 3: Liz Sheridan
Figures 4 and 5: Liz Sheridan
Figure 6: © Anant Kasetsinsombut/123 Royalty Free
Figure 7: Liz Sheridan
Figure 8: EYE OF SCIENCE/SCIENCE PHOTO LIBRARY
Figures 9, 10, 11 and 12: Liz Sheridan
Figures 13, 14, 15, 16, 17 and 18: Liz Sheridan
Figure 19: © ECDC. Dataset provided by ECDC based on data provided by WHO and Ministries of Health from the affected countries
Figure 20: EFSA and ECDC (European Food Safety Authority and European Centre for Disease Prevention and Control), 2021. The European Union Summary Report on Antimicrobial Resistance in zoonotic and indicator bacteria from humans, animals and food in 2018/2019. EFSA Journal 2021;19(4):6490, 179 pp. https://doi.org/10.2903/j.efsa.2021.6490. This file is licensed under the Creative Commons Attribution-NoDerivatives Licence http://creativecommons.org/licenses/by-nd/4.0/
Figure 21: Bonomo, R.A., Burd, E.M., Conly, J., Limbago, B.M., Poirel, L., Segre, J.A. and Westblade, L.F. (2018) 'Carbapenemase-Producing Organisms: A Global Scourge', Clinical Infectious Diseases, Vol. 66, Issue 8, 15 April 2018, Pages 1290–1297. Oxford University Press.
Figure 22: Li, J. et al. (2019) Inter-host Transmission of Carbapenemase-Producing Escherichia coli among Humans and Backyard Animals, Environmental Health Perspectives, Vol. 127, No. 10, https://doi.org/10.1289/EHP5251
Video 1: Liz Sheridan
Table 1: With kind permission of Prof Peter Hawkey, personal communication, University of Birmingham
Table 5: European Committee on Antimicrobial Susceptibility Testing (EUCAST) (2021) ‘Clinical breakpoints – bacteria’, EUCAST.
Every effort has been made to contact copyright owners. If any have been inadvertently overlooked, the publishers will be pleased to make the necessary arrangements at the first opportunity.